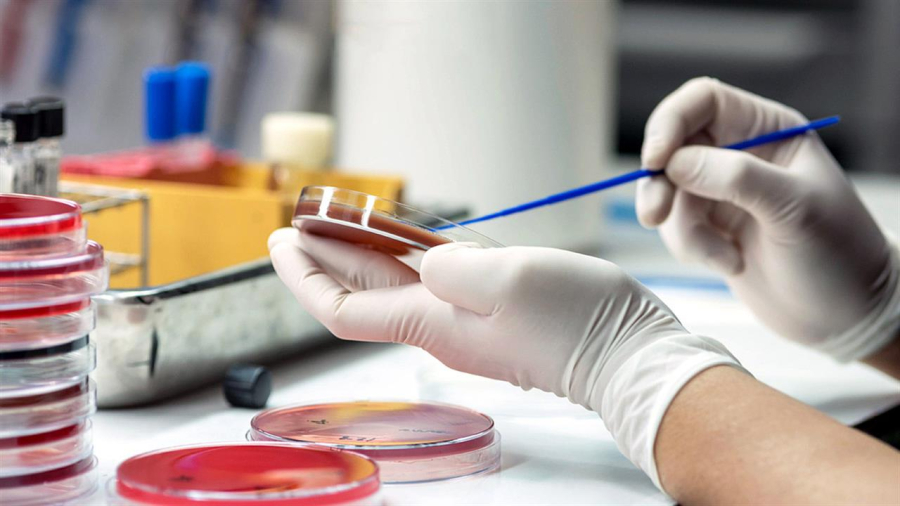
Κλιμάκιο του ΕΟΔΥ στην Πάτρα - Νέο κρούσμα μηνιγγίτιδας σε φοιτητή

Το έτος 2023 η επίπτωση της μηνιγγιτιδοκοκκικής νόσου αυξήθηκε, φτάνοντας σε προπανδημικά επίπεδα και εντός του έτους 2024 έχουν δηλωθεί στον ΕΟΔΥ συνολικά 12 κρούσματα από όλη τη χώρα.
Ειδικότερα, σύμφωνα με τον ΕΟΔΥ, τρία από τα παραπάνω κρούσματα αφορούν φοιτητές πανεπιστημιακών ιδρυμάτων της πόλης της Πάτρας και δηλώθηκαν στον ΕΟΔΥ κατά τη χρονική περίοδο 11/1/2024 ως σήμερα. Σύμφωνα με τις διεθνείς κατευθυντήριες οδηγίες, η ανίχνευση 3 κρουσμάτων μηνιγγιτιδοκοκκικής νόσου της ίδιας οροομάδας σε έναν Οργανισμό (σχολείο, πανεπιστημιακό ίδρυμα, κ.ά.) κατά τη διάρκεια περιόδου τριών μηνών, συνιστά έξαρση κρουσμάτων και συστήνεται η επέκταση της χορήγησης χημειοπροφύλαξης σε ευρύτερο κύκλο από τις στενές επαφές και στοχευμένος εμβολιασμός στις στενές επαφές των κρουσμάτων.
Από την εμφάνιση του πρώτου κρούσματος, ο ΕΟΔΥ βρίσκεται σε στενή συνεργασία με την 6η Υγειονομική Περιφέρεια, τη διεύθυνση Δημόσιας Υγείας της Περιφέρειας Δυτικής Ελλάδας και τις αρμόδιες αρχές των πανεπιστημιακών ιδρυμάτων. Απέστειλε οδηγίες σχετικά με τη διερεύνηση των επαφών των κρουσμάτων και την άμεση χορήγηση χημειοπροφύλαξης. Επιπλέον, κατόπιν σχετικής ενημέρωσης και εντολής από την αναπληρώτρια υπουργό Υγείας, Ειρήνη Αγαπηδάκη, αύριο το πρωί θα πραγματοποιήσει επί τόπου παρέμβαση με τη μετάβαση κλιμακίου και τη συμμετοχή των Κινητών Ομάδων Υγείας (ΚΟΜΥ) του ΕΟΔΥ στην Πάτρα. Το κλιμάκιο θα πραγματοποιήσει ενημερώσεις των φοιτητών που φοιτούν στα τμήματα όπου εμφανίστηκαν τα κρούσματα και θα χορηγήσει χημειοπροφύλαξη στις στενές αλλά και τις ευρύτερες επαφές των κρουσμάτων, ενώ συστήνεται στοχευμένος εμβολιασμός των στενών επαφών, σύμφωνα με τη γνωμοδότηση της Εθνικής Επιτροπής Εμβολιασμών (ΕΕΕ).
Ο ΕΟΔΥ τονίζει ιδιαίτερα τη μεγάλη σημασία που έχει η έγκαιρη ανίχνευση και θεραπεία των κρουσμάτων μηνιγγιτιδοκοκκικής νόσου. Οι πολίτες και κυρίως νεαρά άτομα που έχουν κλινικά συμπτώματα συμβατά με τη νόσο (πυρετό και εξάνθημα) πρέπει άμεσα να απευθύνονται σε ιατρό. Οι ιατροί επί υποψίας μηνιγγίτιδας, πρέπει άμεσα να χορηγούν θεραπεία και να παραπέμπουν σε νοσοκομείο.
Περισσότερες πληροφορίες για τη μηνιγγιτιδοκοκκική νόσο είναι αναρτημένες στην ιστοσελίδα του ΕΟΔΥ Βακτηριακή Μηνιγγίτιδα - Εθνικός Οργανισμός Δημόσιας Υγείας (eody.gov.gr).